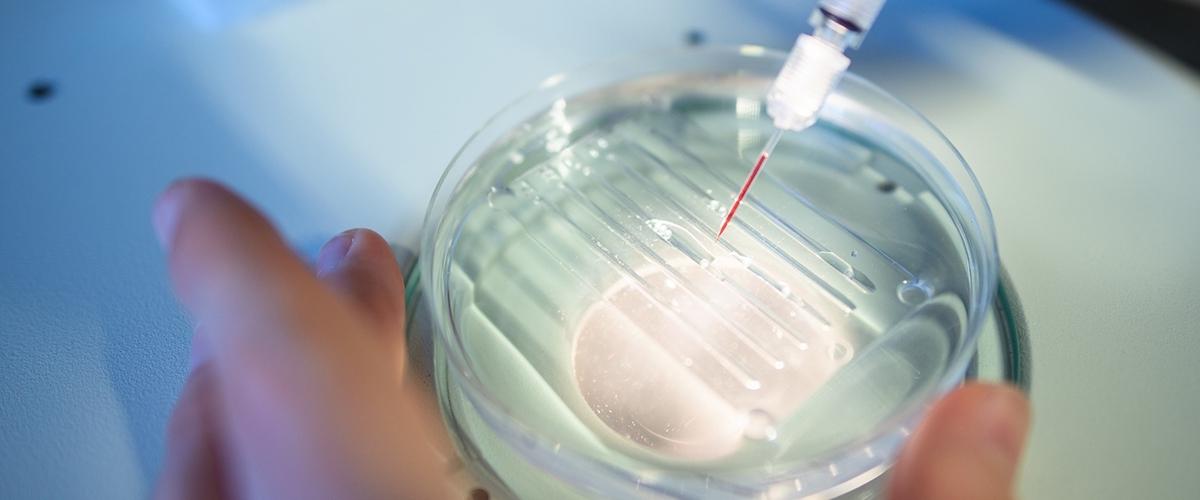

Команда исследователей из Массачусетского технологического университета и Гарварда разработала новый метод редактирования генома. Одним из авторов работы стал Чжан Фэн, стоявший у истоков технологии CRISPR.
Новая методика также основана на системе CRISPR, однако вместо стандартного фермента Cas9 в ней используется Cas12b, выделенный из бактерии Bacillus hisashii. По сравнению с предшественником, новый фермент обладает большей избирательностью и меньшим размером.

Ученые отметили перспективность Cas12b еще в 2015 году, однако у фермента был один серьезный недостаток. Он происходит от термофильных бактерий, населяющих горячие источники, вулканы и гейзеры, и функционирует лишь при высоких температурах. Задачей команды было модифицировать Cas12b для работы при температуре человеческого тела.
Соединив данные о естественном разнообразии бактерий с инструментами конструирования белков, ученые создали версию Cas12b, которая может редактировать иммунные клетки человека.
Семейство ферментов Cas12b привлекает все больше внимания исследователей. Например, в 2017 году команда из Калифорнийского университета в Беркли сообщила о перспективности Cas12b, выделенного из бактерий Alicyclobacillus acidoterrestris. Фермент ее родственницы, Alicyclobacillus acidiphilus, использовался китайскими специалистами для редактирования клеток млекопитающих.
Эксперты допускают, что в природе существует еще множество перспективных систем CRISPR, которые пока неизвестны науке.
В 2018 году технология CRISPR продолжала бурно развиваться. По мнению энтузиастов, эта методика способна изменить целые отрасли человеческой деятельности, от медицины до сельского хозяйства. При этом скептики опасаются непредсказуемых последствий генного редактирования.